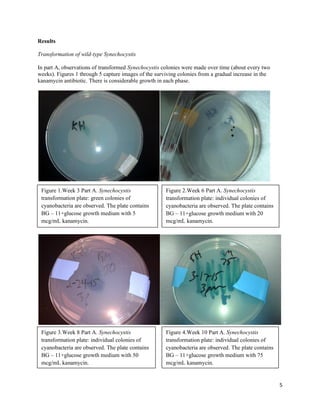
5
Results
Transformation of wild-type Synechocystis
In part A, observations of transformed Synechocystis colonies were made over time (about every two
weeks). Figures 1 through 5 capture images of the surviving colonies from a gradual increase in the
kanamycin antibiotic. There is considerable growth in each phase.
Figure 1.Week 3 Part A. Synechocystis
transformation plate: green colonies of
cyanobacteria are observed. The plate contains
BG – 11+glucose growth medium with 5
mcg/mL kanamycin.
Figure 2.Week 6 Part A. Synechocystis
transformation plate: individual colonies of
cyanobacteria are observed. The plate contains
BG – 11+glucose growth medium with 20
mcg/mL kanamycin.
Figure 3.Week 8 Part A. Synechocystis
transformation plate: individual colonies of
cyanobacteria are observed. The plate contains
BG – 11+glucose growth medium with 50
mcg/mL kanamycin.
Figure 4.Week 10 Part A. Synechocystis
transformation plate: individual colonies of
cyanobacteria are observed. The plate contains
BG – 11+glucose growth medium with 75
mcg/mL kanamycin.

This experiment transformed the cyanobacterium Synechocystis sp. PCC 6803 in two parts. Part A introduced a mutation to the psbC gene, which encodes a chlorophyll-binding protein, via a plasmid. This disrupted photosystem II and allowed selection of transformed cells. Part B amplified the wild-type psbC gene, cloned it into a plasmid, and transformed mutant cells to restore photosystem function. Various DNA manipulations, transformations, and selections were performed to characterize and select transformed cells at each step.